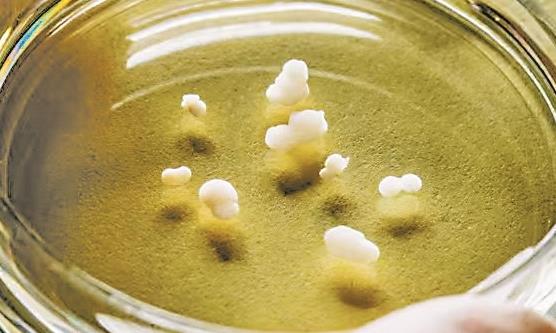

|

|

|

|

|

|

|

|

|

|

|

|

|

|

|

|

|

|

|

|

|

|

|

|

|

|

|

|
|
卡城新闻 加国新闻 即时新闻 娱乐八卦
最新科技 读者文摘 养生保健 美食饮品
居家生活 移民茶馆 艺术中心 风筝专辑 房屋租赁 求职招聘 便民广告 定居指南 城市介绍 房产动态 留学移民 华人故事 教育话题 财经信息 精华旅游 难得一笑 |

|

|

|

|

|

|

|

|

|

|

|

|

|

|

|

|

|

|

|

|

|

|

|

|

|

|

|

|
|
卡城新闻 加国新闻 即时新闻 娱乐八卦
最新科技 读者文摘 养生保健 美食饮品
居家生活 移民茶馆 艺术中心 风筝专辑 房屋租赁 求职招聘 便民广告 定居指南 城市介绍 房产动态 留学移民 华人故事 教育话题 财经信息 精华旅游 难得一笑 |

|

|

|

|

|

|

|

|

|

|

|

|

|
|
卡城新闻 加国新闻 即时新闻 娱乐八卦 最新科技 读者文摘 养生保健 美食饮品 居家生活 移民茶馆 艺术中心 风筝专辑 房屋租赁 求职招聘 便民广告 定居指南 城市介绍 房产动态 留学移民 华人故事 教育话题 财经信息 精华旅游 难得一笑 |
| 最新科技 |
 卡城华人网信息中心 卡城华人网信息中心  最新科技 最新科技
  脑类器官研究步入快车道 脑类器官研究步入快车道
|
|
【卡城华人网 www.calgarychina.ca】 2026-04-15 11:26 免责声明: 本消息未经核实,不代表网站的立场、观点,如有侵权,请联系删除。 |
|
【科技创新世界潮】 ◎本报记者 刘 霞 长久以来,科学家探究大脑机制主要依赖动物模型与稀缺的人体脑组织。如今,实验室培育的“微型大脑”类器官(脑类器官)的问世,彻底打破了这一研究瓶颈。
据英国《自然》杂志网站近日报道,类器官技术于十余年前初现雏形,近年来,随着培养工艺的不断精进,脑类器官研究正步入快车道,科学家已构建出涵盖多脑区、结构更趋复杂的脑类系统。这些“微型大脑”正被用于解析发育轨迹,模拟孤独症、精神分裂症等神经发育障碍,并作为新药筛选与疗效评估的平台。奥地利维也纳分子生物技术研究所发育生物学家尤尔根·克诺布利希直言,该领域正迎来历史性的转折点。 “微型大脑”百花齐放 上世纪80年代,美国哲学家希拉里·普特南提出了著名的“缸中之脑”思想实验。几十年后,科学家开始在培养皿中将这一哲学构想化为现实——脑类器官。它是由人类干细胞培育而成的微小球体,内部自组织形成初级的类脑结构。 2013年,克诺布利希与英国剑桥大学发育生物学家玛德琳·兰卡斯特在《自然》杂志发表论文,报告了全球首个源自人类多能干细胞的三维脑类器官。团队利用生物凝胶模拟脑外基质,借助生物反应器优化营养输送与氧气扩散,并添加特定生长因子诱导神经发育,最终培育出结构相对完整的类器官。该模型已能呈现前脑、脉络丛、海马及前额叶等多个既独立又互联的脑区雏形。 此后,脑类器官研究步入快车道。全球科研团队不断优化诱导配方,通过精准调控小分子与生长因子组合,相继培育出中脑、丘脑、小脑、纹状体等具有特定脑区特征的类器官。 随着技术迭代,科学家开始尝试将两个或多个脑区类器官进行拼接,构建“类器官组合体”,以更逼真地模拟真实大脑的发育轨迹与神经元迁移过程。美国斯坦福大学塞尔吉乌·帕什卡团队已构建数十种组合体,融合脊髓、大脑皮层与肌肉类器官。 尽管组合体已成为神经发育实验室的“新宠”,但这种“乐高式”的人工拼接仍缺乏生理自然性。去年7月,美国约翰斯·霍普金斯大学研究团队在《先进科学》杂志发表研究成果称,他们培育出新型“全脑”类器官。该模型不仅整合了多脑区神经组织,更首次引入了初步的血管网络,标志着类器官向“统一运作、自给自足”的微型脑系统迈出了关键一步。 破解发育和疾病奥秘 脑类器官的成熟,为科学家解答人类独有的进化谜题提供了“时间显微镜”。例如:为何人脑发育节奏远缓于其他哺乳动物?要知道,人类神经元的成熟周期约为小鼠的10倍,每一步都漫长而精密。 类器官模型帮助科学家锁定了一些关键物种差异,如代谢速率放缓、信号通路重塑及特定基因表达模式的改变。遗传学家认为,人类的认知独特性,或许正源于数百种低强度基因调控的叠加效应,它们精准地启闭特定脑区的特定基因。 在疾病研究与治疗领域,类器官同样展现出破局潜力。因为精神分裂症、孤独症、阿尔茨海默病等往往累及全脑网络而非单一区域。借助“全脑”类器官,科学家有望在病程极早期捕捉病变起源,进而发现全新治疗靶点。 然而,跨时空模拟仍是巨大挑战。若要研究青少年期乃至成年后的大脑发育,科学家不愿等待类器官在体外自然生长10年之久,他们渴望将长达15至20年的发育进程压缩至数月内,但这绝非易事。 目前,已经有一种小分子组合,可在体外促使神经元加速成熟数周,提升线粒体(细胞能量工厂)功能亦可达到类似效果。但这些“催熟”手段会否扭曲细胞的真实功能,仍是未知数。 相较之下,部分临床应用已触手可及。今年,全球首个基于类器官研发的疗法将正式迈入临床试验。该疗法靶向蒂莫西综合征——一种因基因突变导致神经元迁移受阻,进而引发癫痫与孤独症的罕见病。科学家已在组合体模型中成功修复了遗传缺陷。 人脑的奥秘远未穷尽。未来10年,这类干细胞模型将继续成为揭示复杂脑疾生物学基础的利器,为人类攻克曾被视为“黑箱”的神经系统疾病照亮前路。 安全与伦理问题值得警惕 脑类器官技术狂飙突进的同时,伦理和安全隐忧如影随形。 随着类器官结构日趋复杂,它们是否可能衍生出感知能力甚至初级意识?意大利米兰大学分子神经科学家朱塞佩·特斯塔明确表示,目前尚无迹象表明这些类器官具备任何形式的感知能力或意识。但随着复杂度提升,科学界必须建立持续监测机制,敏锐捕捉培养皿中可能出现的异常复杂行为。 尽管类器官技术旨在减少对传统动物实验的依赖,但长期维持其体外活性仍面临瓶颈。为此,部分科学家尝试将其移植至活体啮齿动物脑内。然而,跨物种脑组织嵌合引发了学界的深切担忧。如何在推动研究与恪守伦理底线之间取得平衡,已成为亟待确立的规范。 此外,更多前沿伦理议题浮出水面:脑类器官未来是否可能与计算机系统对接?脑机融合将衍生何种社会后果?提供干细胞的捐赠者是否有权限定其组织的研究用途?尽管部分担忧尚属前瞻性探讨,但专家们认为,指导原则与监管框架必须先行。唯有在敬畏生命的前提下大胆探索,类器官技术方能真正惠及人类健康未来。 来源:科技日报 编辑(Edit) 删除(Delete) |

|

|

|
| 版权所有(C), 2002-2026, 卡城华人网中国版 www.calgarychina.ca |
| 版权所有(C), 2002-2026, 卡城华人网中国版 www.calgarychina.ca |